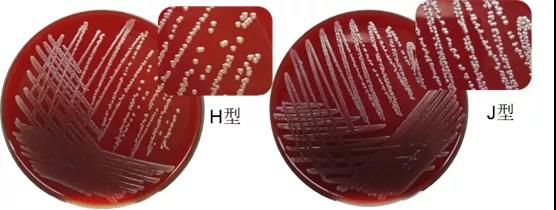
215.jpg

病原体简介
根据我国国标要求,嗜肺巴斯德杆菌(Pasteurella pneumotropica)是SPF级实验大小鼠必须排除的项目之一,也被认为是啮齿类实验动物中最重要的巴氏杆菌科物种之一。
而实际上嗜肺巴斯德杆菌的构成较为复杂,更准确的说,这类细菌应该称为“嗜肺巴斯德杆菌复合体”。
按照以往的分类,嗜肺巴斯德杆菌主要包括两种生物型:Jawetz型(J型)和Heyl型(H型),另外还有一些既不属于J型又不属于H型的临床分离株。
由于分类的模糊性,以往发表的文章常常没有具体描述嗜肺巴斯德杆菌的生物型,容易使人困扰。
Adhikary等人收集了大量数据,于2017年将嗜肺巴斯德杆菌及其密切相关的巴氏杆菌重新分类为“啮齿杆菌属”(Rodentibacter genus)的8个不同种,这8种细菌可以通过表型特征相互区分。包括:
嗜肺啮齿杆菌(Rodentibacter pneumotropicus,即原嗜肺巴斯德杆菌J型)
啮齿杆菌H型(Rodentibacter heylii,即原嗜肺巴斯德杆菌H型)
Rodentibacter ratti
Rodentibacter myodis
Rodentibacter heidelbergensis
Rodentibacter trehalosifermentans
Rodentibacter rarus
Rodentibacter mrazii
本文会将有具体分型的菌株称为重新分类后的名称,没有具体分型的称为“啮齿杆菌”。
啮齿杆菌属,特别是R. pneumotropicus 和 R. heylii已被报道为实验室小鼠和大鼠最常见的感染。
由于啮齿杆菌的高流行率及其对动物实验和福利的重要影响促使欧洲实验室动物科学协会联合会(FELASA)建议对实验室啮齿动物生产和使用单位的啮齿杆菌感染进行检测和报告,国外主要实验动物供应商也普遍将它们列入自己的监测范围。
我国国标也将“嗜肺巴斯德杆菌”作为SPF实验大小鼠必须排除的项目。但也有少数设施或研究者没有将它们列入必须排除的病原体列表。
流行病学
巴氏杆菌科成员中,除了多杀巴斯德杆菌可以感染更广泛的宿主,其他成员似乎都只与一种或少数几种密切相关的宿主有关。
而啮齿杆菌主要感染啮齿类动物,除了实验大小鼠,宠物鼠、野鼠也都可感染。
通常,从小鼠中分离到的啮齿杆菌通常既可以感染小鼠又可以感染大鼠,而自大鼠中分离到的啮齿杆菌则不容易感染小鼠,这表明来自大鼠的菌株具有更强的种属特异性。
实验大小鼠最常见污染源来自感染的动物,另外受污染的生物材料,如肿瘤和细胞系也可以将啮齿杆菌引入实验动物群体。
实验动物设施内较高的检出率则表明啮齿杆菌具有良好的传播能力。
在一个阳性的群体中,啮齿杆菌在小鼠出生时可通过产道传播给仔鼠,也可通过气溶胶、唾液等传播给同一生活环境中的小鼠。
由于啮齿杆菌无法在环境中存活太长时间,例如,在动物房中,R. heylii在鼠毛发上最长仅可存活120分钟,甚至其纯培养物在血琼脂培养基上存活也不会超过一周,因此通过垫料、饲料等间接接触传播的可能性较小。
也正是由于这种特性,许多研究都指出,通过脏垫料哨鼠检测这种病原体的效果不佳,但直接接触法的哨兵鼠可以快速感染。
根据第三方检测机构苏州西山生物的检测数据,2021年,我国实验动物啮齿杆菌的检出率为 4.5%(n=9057)。
发病机制
啮齿类动物感染啮齿杆菌后主要定植于上呼吸道,眼部粘膜和中耳的定植也经常发生,因为它们在解剖学上靠近上呼吸道,此外生殖系统黏膜也是常见的定植地点。
研究表明,R. heylii在鼻腔定殖后的很短时间内,免疫系统就会产生β-IL-1、α-TNF、CCL3、CXCL1和CXCL2等细胞因子进入局部淋巴结。而是否会发展出进一步的临床症状取决于一系列因素,如环境、遗传背景或其他感染。
有研究显示MHCⅡ、Tlr4和Nramp1基因似乎对减少小鼠肺部感染发挥了重要作用。
此外,TLR4引发的免疫防御机制似乎也对早期识别和清除啮齿杆菌肺部感染很重要。
但总的来说,目前对啮齿杆菌感染的发病机制的认识非常有限,未来在这方面的研究很有必要。
临床症状
总体而言,啮齿杆菌感染实验啮齿类动物后是不会导致临床症状的,但作为一类条件致病菌,它也有机会使动物出现健康问题,有时候甚至可能是主要致病原因,当有其他病原体同时存在时将加重病情,也会作为继发感染因子影响动物健康。
其中,免疫缺陷动物通常更容易发展出临床症状。啮齿杆菌感染导致的临床症状通常包括:
眼眶脓肿和结膜炎等眼部问题;
打喷嚏、鼻腔黏膜炎症和坏死等;
也可见中耳炎病例;并可引起流产、子宫炎、死胎和不孕症等;
雄性小鼠还会出现肾盂肾炎、肾脓肿、生殖系统脓肿等。
有研究证实,当啮齿杆菌与其他病原体例如肺支原体、仙台病毒、卡氏肺孢子虫等共同感染时,会表现出更严重的临床症状和病理变化。
除了免疫缺陷和共同感染外,啮齿杆菌在大小鼠中的致病性还受宿主基因型、环境和实验等因素影响。
例如,较高的湿度、低温、较高的氨浓度、实验带来的应激和压力等都可能成为诱发因子。
人类感染啮齿杆菌的案例非常罕见,其人兽共患风险非常小。

啮齿杆菌感染导致的眼周脓肿
检测和鉴定
目前国标推荐且最广泛应用的方法是分离培养,通过生化分析细菌表型来鉴定。
但由于分类的不明确和对啮齿杆菌的表型缺乏深入了解,因此这类细菌准确鉴定具有一定挑战性,现有的商业化鉴定试剂如API 20 NE对部分临床株的鉴定结果存在一定问题。
PCR方法也被广泛应用于啮齿杆菌的检测和鉴定,但由于多种生物型的存在,应谨慎选择引物,并充分验证方法。
由于该类细菌本身的特性,用传统培养法检测会存在一定概率的漏检,例如样本送到检测实验室时细菌已经失去活性,或者由于其他杂菌生长掩盖和抑制了啮齿杆菌菌落,由于表型的不确定出现漏检或误判等。如果是基于培养法监测和筛选时,应特别注意这一点。
不论用什么检测方法,所需的检测样本都包括:鼻拭子、气管拭子、肠内容物拭子、病灶分泌物拭子等。
R. heylii和 R. pneumotropicus 在血平皿上的菌落形态
治疗和预防
在实验动物管理中,可通过采取一系列措施预防啮齿杆菌感染,例如:有效的消毒措施、防止野生动物进入设施、对新进动物进行检疫、对已经在设施的动物进行定期监测等。
已经发生感染的动物如果需要净化,最彻底的办法是胚胎移植。
对感染动物的抗生素治疗也是清除啮齿杆菌的一种选择,特别是当感染的动物是珍贵的品系时。
多项研究显示,口服恩诺沙星可以有效消除污染的小鼠群体中的啮齿杆菌。
参考文献:
1. A L B , A M S , B H C . From the [ Pasteurella ] pneumotropica complex to Rodentibacter spp.: an update on [ Pasteurella ] pneumotropica[J]. Veterinary Microbiology, 2018, 217:121-134.
2. 王立鹏, 李永旺, 王晨娟,等. Dole qPCR检测嗜肺巴斯德杆菌的可靠性研究及在啮齿类实验动物质量监测中的应用[J]. 现代检验医学杂志, 2019, 34(5):6.



